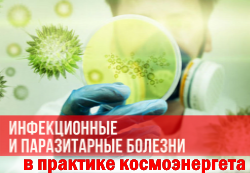

Программа обучения →
Самопознание. Практикам на заметку →
Виды негативных программ →
Магия камней и минералов →
Свечная магия и воскотерапия →
Магия стихий →
Магия растений →
Медитации →
Эзотерический словарь, справочник →
Знахарь — разное познавательное →
![]()
♦ Диагностика:
♦ Диагностика здоровья по проекционным зонам →
♦ Диагностика здоровья по лицу и шее →
♦ Позвоночник: 6 страхов, которые порождают болезни →
♦ Диагностика энергопотенциала (аура-чакры) и общего состояния здоровья →
♦ Позвоночник. Карта вашего тела на позвоночном столбе →
♦ Наш организм и его сигналы →
♦ Рефлексотерапия — диагностика здоровья по стопам ног→
♦ Рефлексотерапия — диагностика по кистям рук →
♦ Психология болезней тела →
♦ Диагностика по языку →
Анатомия и нестандартные болезни — диагностика и методы — статьи на тему
♦ Функциональные системы организма→
♦ Костно-мышечная система →
∠.. Пяточная шпора → Деформация стопы → Бурсит стопы → Синдром беспокойных ног → Сколиоз, плоскостопие, косоглазие, кривые зубы → Почему немеют руки→
♦ Покровная система (Кожа, волосы, ногти) →
∠.. Диагностика здоровья по ногтям → Шипица → Аллергия, псориаз, красная волчанка →
Целительство — прочие состояния и болезни:
∠.. Тревожные признаки грибков в организме →
∠.. Инфекционные и паразитарные болезни →
∠.. Аллергия, псориаз, красная волчанка →
∠.. Удалить гланды и аппендикс — это все равно, что отрезать кусок иммунной системы→
Целительство — нестандартные состояния (магия, эзотерика, мистика):
♦ Диагностика порчи. Выкатывание яйцом→
♦ Вдовий горб→
![]() |
![]() |
![]() |
![]() |
![]() |
![]() |
![]() |
![]() |
![]() |
![]() |
![]() |
![]() |
![]() |
![]() |
![]() |
![]() |
![]() |
![]() |
![]() |
![]() |
![]() |
![]() |
![]() |
![]() |
![]() |
||